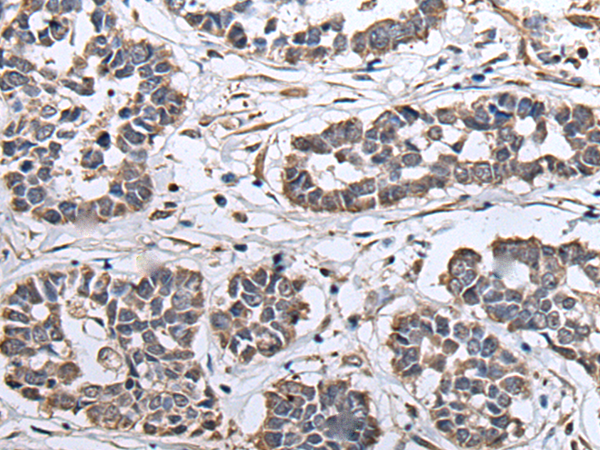

中文名稱(chēng):兔抗ZNHIT1多克隆抗體
|
Background: |
ZNHIT1 (zinc finger, HIT-type containing 1), also known as CG1I (cyclin-G1-binding protein 1), p18 hamlet or ZNFN4A1 (zinc finger protein subfamily 4A member 1), is a 154 amino acid protein that plays a role in the induction of p53-mediated apoptosis. A member of the ZNHIT1 family, ZNHIT1 contains one HIT-type zinc finger and interacts with p38. ZNHIT1 undergoes post-translational phosphorylation and is encoded by a gene that maps to human chromosome 7, which houses over 1,000 genes and comprises nearly 5% of the human genome. Chromosome 7 has been linked to Osteogenesis imperfecta, Pendred syndrome, Lissencephaly, Citrullinemia and Shwachman-Diamond syndrome. The deletion of a portion of the q arm of chromosome 7 is associated with Williams-Beuren syndrome, a condition characterized by mild mental retardation, an unusual comfort and friendliness with strangers and an elfin appearance. |
|
Applications: |
ELISA, IHC |
|
Name of antibody: |
ZNHIT1 |
|
Immunogen: |
Full length fusion protein |
|
Full name: |
zinc finger HIT-type containing 1 |
|
Synonyms: |
CG1I; ZNFN4A1 |
|
SwissProt: |
O43257 |
|
ELISA Recommended dilution: |
5000-10000 |
|
IHC positive control: |
Human thyroid cancer and human esophagus cancer |
|
IHC Recommend dilution: |
25-100 |

購(gòu)物車(chē)
購(gòu)物車(chē) 幫助
幫助
 021-54845833/15800441009
021-54845833/15800441009
